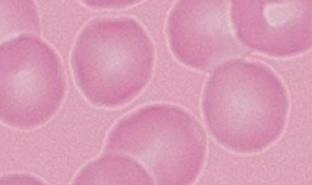
<p>Name the cells</p>
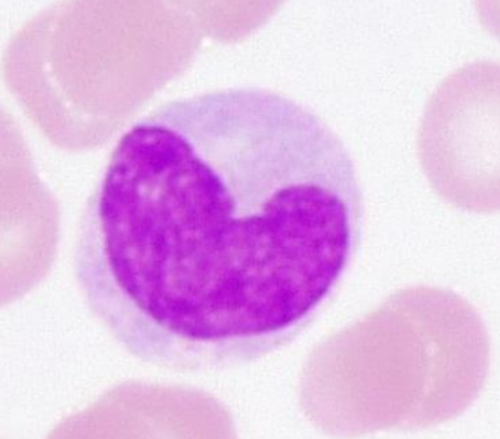
<p>Name the cell</p>
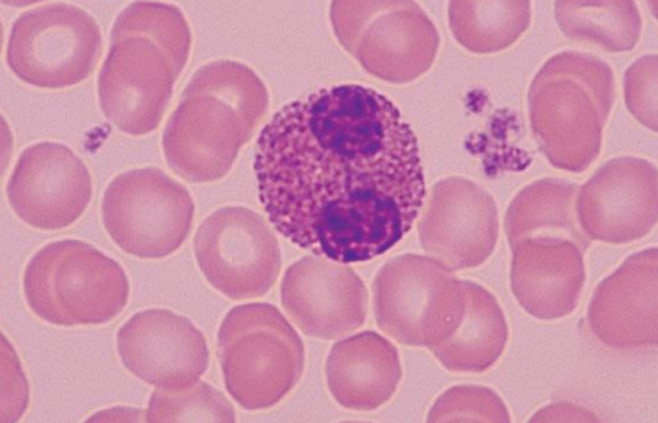
<p>Name the cells SURROUNDING the eosinophil</p>
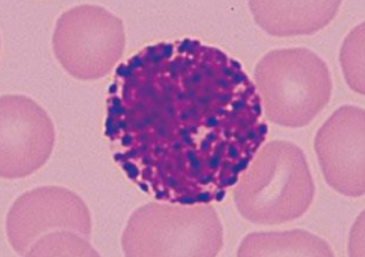
<p>Name the cell</p>
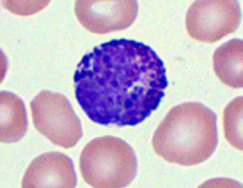
<p>Name the cell</p>
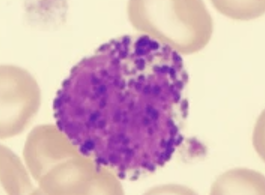
<p>Name the cell</p>

Histology
1/46
There's no tags or description
Looks like no tags are added yet.
Name | Mastery | Learn | Test | Matching | Spaced |
|---|
No study sessions yet.
47 Terms

What cross section is this?
Skeletal muscle

What is the BLUE arrows pointing to?
epimysium

What is the YELLOW arrows pointing to?
endomysium

What is the GREEN arrows pointing to?
perimysium

What is the pointer on?
perimysium

This is a cross section of what?
Skeletal muscle

What muscle is this?
Skeletal muscle

What muscle is this?
Cardiac muscle

What is the pointer on?
intercalated disc

What muscle is this?
Cardiac muscle

What are the black arrows pointing to?
intercalated discs

What muscle is this?
Smooth muscle

What are the arrows pointing to?
Nuclei

What muscle is this?
Smooth muscle

What is the pointer on?
Axon of a somatic motor neuron

What are the GREEN arrows pointing to?
Neuromuscular Junction

What are the YELLOW arrows pointing to?
Axon of a somatic motor neuron.

What is the WHITE arrow pointing to?
skeletal muscle fiber

What is the pointer on?
axon of a somatic motor neuron

What is the pointer on?
vasa vasorum

What is the pointer on?
vasa vasorum

Name the blood vessel in the blue circle
Vein

Name the blood vessel in the red circle
artery

Name number 1
Tunica externa

Name number 2
Tunica media

Name number 1
Tunica externa

Name number 2
Tunica media

Name the cell
Neutrophil

Name the cell
Neutrophil
Name the cells
Erythrocytes

Name the cell
Lymphocyte

Name the cell
lymphocyte

Name the cell
lymphocyte
Name the cell
Monocyte

Name the cell
Monocyte

Name the cell
Monocyte

Name the cell
monocyte

Name the cell
neutrophil

Name the cell
Eosinophil

Name the cell
Eosinophil
Name the cells SURROUNDING the eosinophil
Erythrocytes

Name the cell
Eosinophil

Name the cell
Eosinophil
Name the cell
Basophil

Name the cell
Basophil
Name the cell
Basophil
Name the cell
Basophil